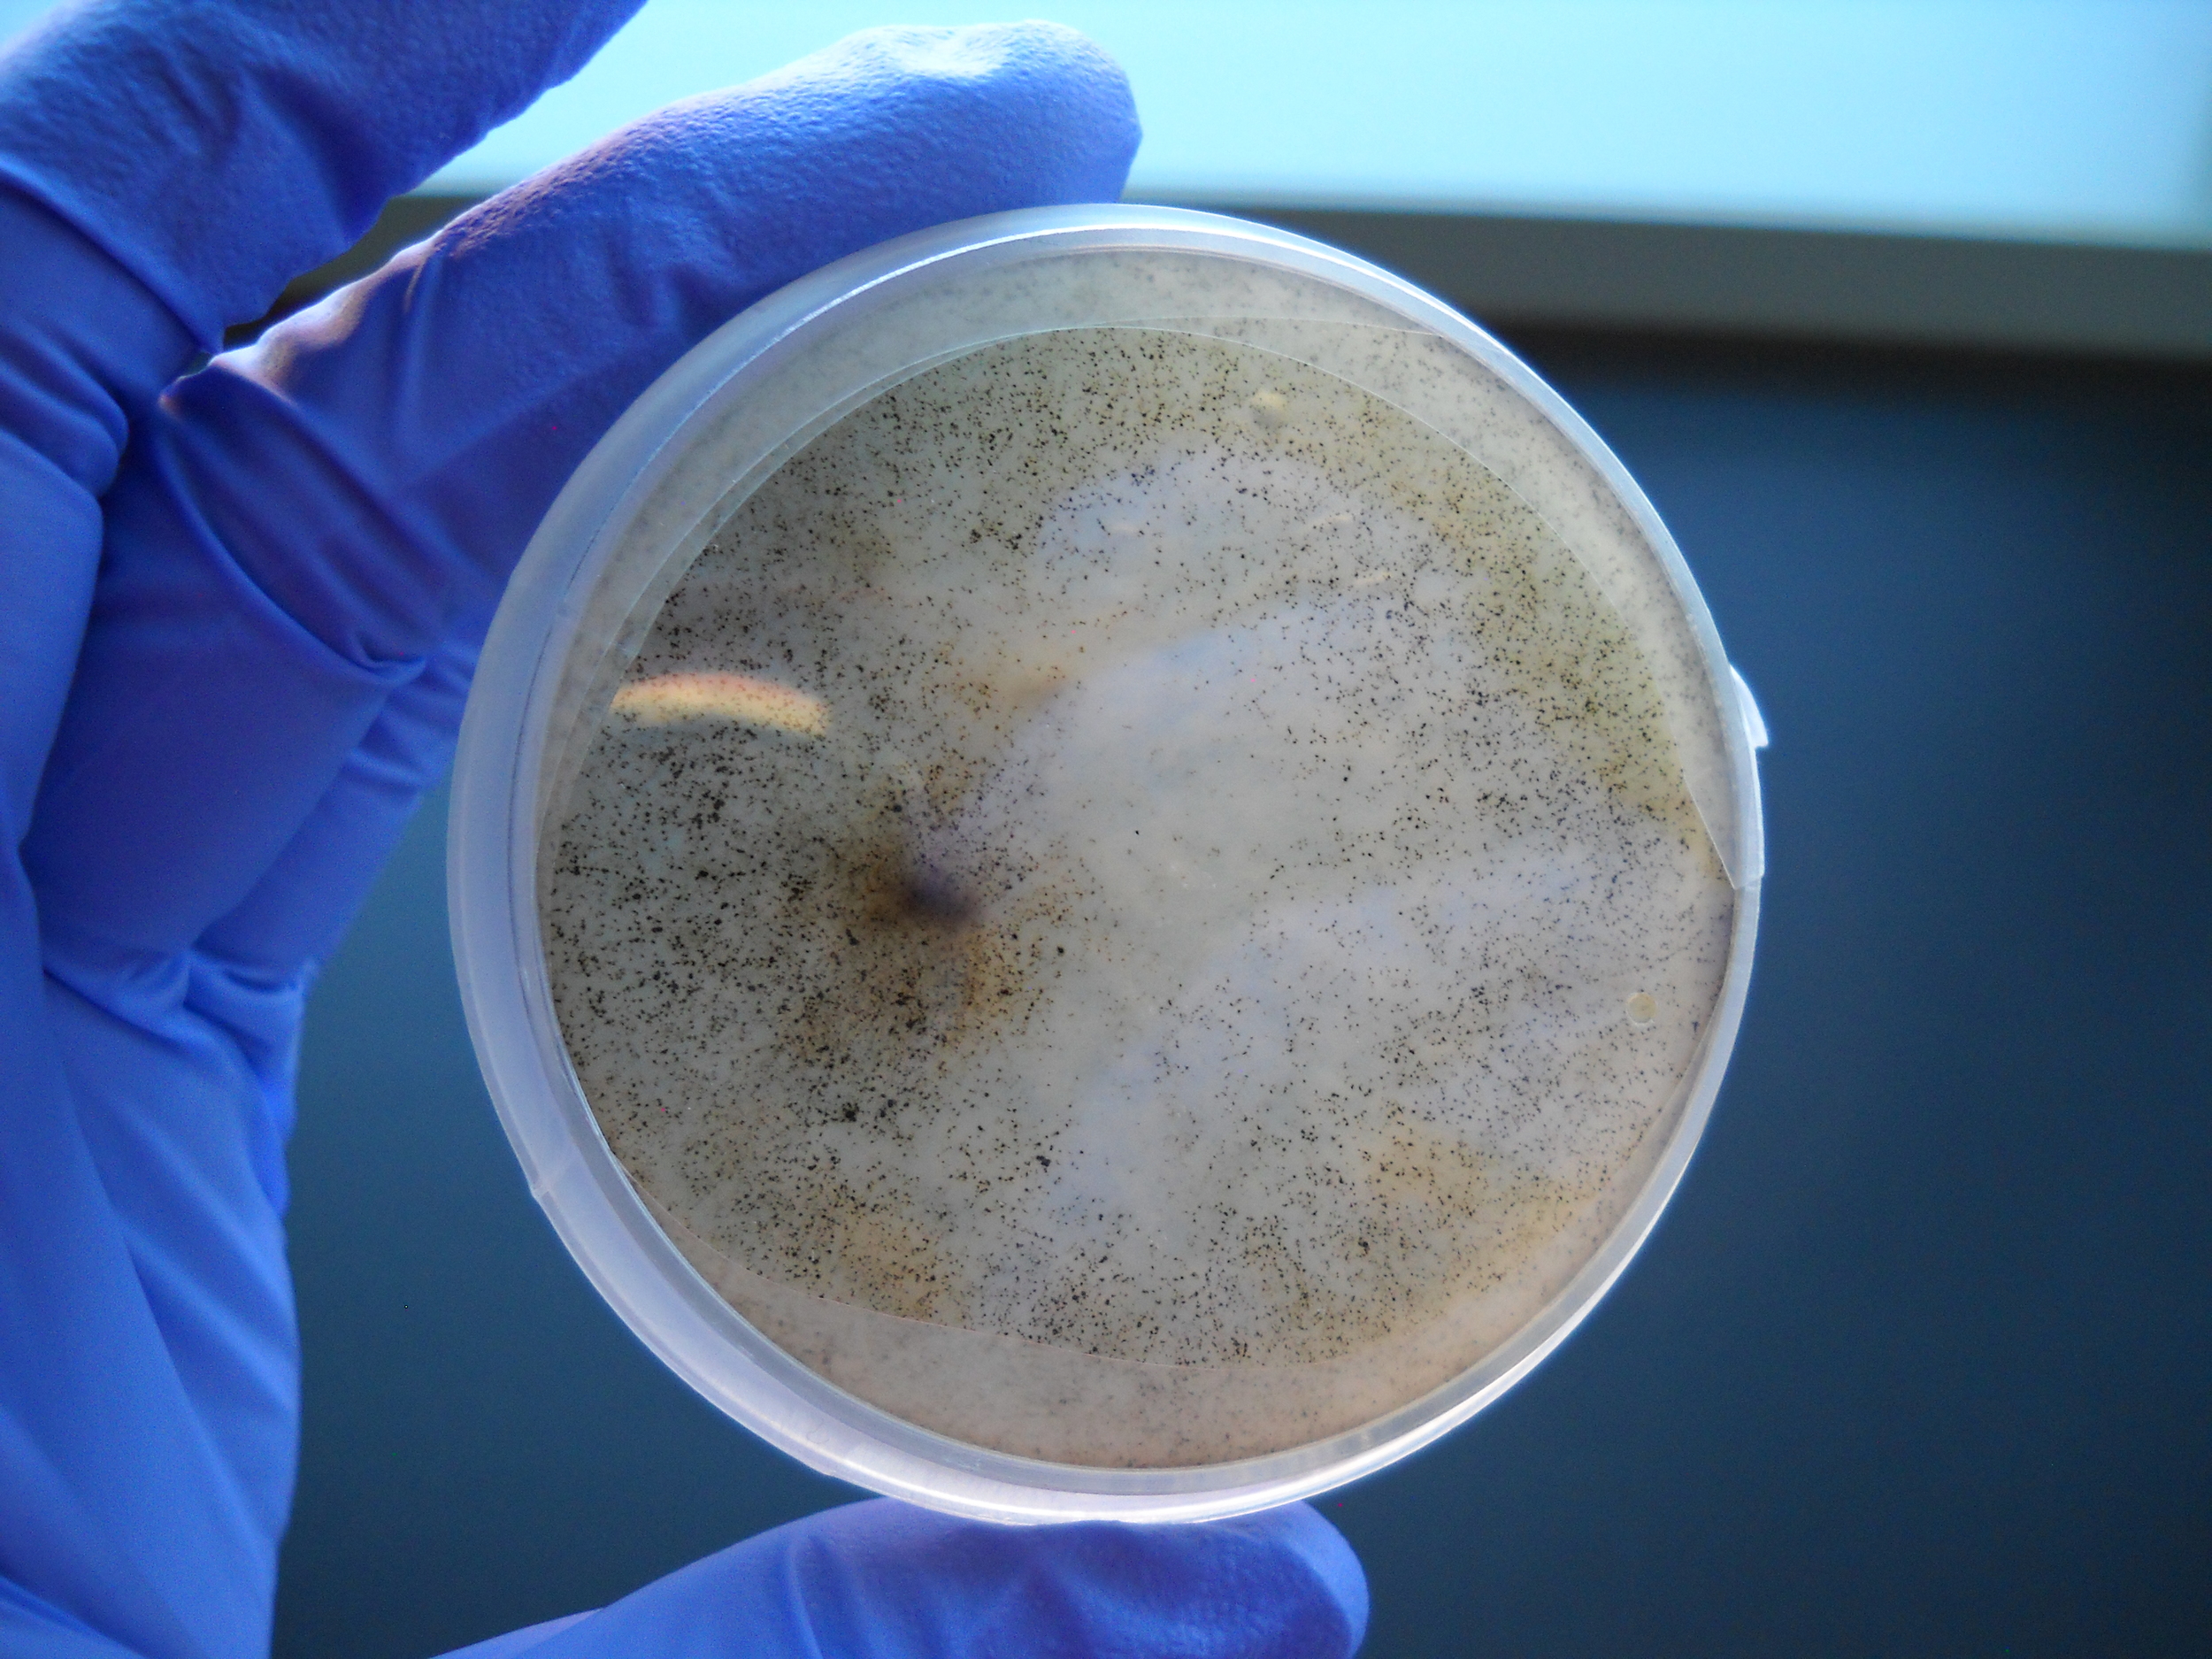
Sample32bottomofPlate.JPG

Mordecai Lab, Stanford University
Erin Mordecai is an associate professor in Biology at Stanford University.
Mordecai Lab, Stanford University
Erin Mordecai is an associate professor in Biology at Stanford University.
erin mordecai
Erin Mordecai is an assistant professor in Biology at Stanford University.
Our research focuses on the ecology of infectious disease. We are interested in how climate, species interactions, and global change drive infectious disease dynamics in humans and natural ecosystems. This research combines mathematical modeling and empirical work.
Smut fungus
Avena fatua in Pearson-Arastradero Park,
Palo Alto, California.
Rust fungus
Elymus glaucus in Jasper Ridge Biological Preserve, Woodside, California.
Leaf spot
Pisonia grandis leaf on Palmyra Atoll.

Our Research
Work in the lab uses mathematical models and empirical data to study the ecology of infectious diseases
Our Research
Work in the lab uses mathematical models and empirical data to study the ecology of infectious diseases
Environmental drivers of vector-borne disease
Anthropogenic environmental change is pervasive, rapid, and multifaceted. Climate change, human population growth and urbanization, land use change, and species invasions and extinctions are reshaping ecological communities and with them, infectious disease dynamics. Our work investigates the environmental drivers of disease, including climate, land use, and human interactions with the environment in a variety of mosquito-borne diseases. We are studying impacts of climate and socio-economic factors on arboviruses like dengue, chikungunya, and Zika in Kenya, Ecuador, and Costa Rica (in collaboration with Desiree LaBeaud, Eric Lambin, Anna Stewart Ibarra, Sadie Ryan, Taylor Ricketts, Adriana Troyo, and others, funded by the Stanford Woods Institute for the Environment – Environmental Ventures Program). We are also investigating the impacts of deforestation on malaria in the Amazon (in collaboration with Andy MacDonald, Lisa Mandle, and others at the Natural Capital Project, funded by the Moore Foundation and the NSF EEID program). We also receive support from an NIGMS MIRA grant (1R35GM133439-01). Images: Erin Mordecai & Chris Anderson.
Effects of temperature on vector-transmitted diseases
Mosquitoes and other biting insects transmit many of the most important, devastating, and neglected human infectious diseases, including malaria, dengue, chikungunya, and West Nile virus. Because these disease vectors are small-bodied and cold-blooded they are sensitive to environmental temperature. As a result, climate change is likely to shift the global distribution of these vector-borne diseases. We have used laboratory data and a mathematical model to show that thermal responses of traits involved in malaria transmission are nonlinear, and that the resulting optimum temperature for malaria transmission is just 25°C. The model allows us to make nuanced predictions about where climate change may most impact malaria transmission. In a project funded by the National Science Foundation Ecology and Evolution of Infectious Diseases Program (DEB-1518681), we are working to predict thermal responses in a range of vector-borne diseases, to map these predicted changes, and to estimate their uncertainty using mathematical models and Bayesian statistics. Our work will also explore local thermal adaptation in two key mosquito species that transmit dengue, chikungunya, Zika, and yellow fever viruses: Aedes aegypti and Aedes albopictus. Collaborators include Leah Johnson, Sadie Ryan, Krijn Paaijmans, Samraat Pawar, Kevin Lafferty, Jason Rohr, Van Savage, Matt Thomas, Anna Stewart Ibarra, Courtney Murdock, and others. Images: Erin Mordecai & Krijn Paaijmans.
Pathogen impacts on plant communities
Parasitism is one of the most common strategies of life on earth, and natural plant communities host a huge diversity of pathogens. Our work examines feedbacks between pathogen and host communities in California grasslands and other systems. We grew fungal pathogens of native and exotic grasses in culture to identify the pathogen community in this vast and heavily invaded ecosystem. In tandem, we experimentally measured pathogen impacts on plant competition and other demographic rates. Combined with mathematical models, this work helps us understand how pathogens affect the composition of plant communities. We are particularly interested in how generalist pathogens that can be transmitted between host species may indirectly modify competition. This work takes place in the amazing and beautiful Jasper Ridge Biological Preserve, just seven miles from Stanford University main campus. Images: Erin Mordecai.
Eco-Evolutionary Drivers of Mosquito - Parasite Interactions
Mosquitoes, like almost every other organism on Earth, interact with their own parasites that can limit population growth, individual fitness, and evolutionary trajectories. We are developing the western tree hole mosquito (Aedes sierrensis) and their natural ciliate parasite (Lambornella clarki) as a model system for studying the ecology and evolution of host - parasite dynamics in the wild. The ciliate is a facultative parasite that undergoes irreversible cell differentiation in the presence of mosquito larvae, which act as predators on free-living ciliates. Mosquitoes (as predators) can regulate ciliate populations, ciliates (as parasites) can regulate mosquito populations, and the two can co-occur or exclude one another in tree hole habitats in nature. We are interested in whether climate drives gradients in parasitism rates, mosquito abundance, and mosquito adaptation to both temperature and a lethal parasite. We plan to develop laboratory and field experiments, field observations, and mathematical models to investigate the dynamics of this fascinating system. Collaborators include Otto Seppälä, Jan Washburn, Angie Nakano, and others at the Alameda and San Mateo County Mosquito Abatement Districts. Images: Erin Mordecai and Angie Nakano.